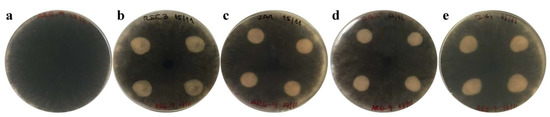

Abstract
Some Plant Growth-Promoting Rhizobacteria (PGPR) can induce protection against pathogens, increasing plant tolerance to various diseases. This so-called biocontrol activity is replacing harmful practices in agriculture caused by the use of agrochemicals. Azospirillum brasilense is one of the PGPR already effectively used as a resistance inducer in several crops. The aim of this study was to evaluate the protective effect of PGPR A. brasilense strains isolated from strawberry and petunia plants (REC3, 2A1, 2A2, and 2E1) against the fungal pathogen Macrophomina phaseolina, which is the causal agent of the strawberry charcoal rot disease. In vitro antagonism assays and enzymatic tests on Petri dishes revealed no direct inhibition on M. phaseolina growth by any of the A. brasilense strains. However, strawberry plants treated with REC3 and 2A1 strains increased callose and lignin deposition and stomatal closure compared to untreated plants. In addition, treatments with either bacterial strains induced a defense response in strawberry plants against virulent isolates of M. phaseolina evidenced by an increased tolerance to the charcoal rot disease. These results suggest that A. brasilense REC3 and 2A1 strains can be used for the activation of innate immunity in strawberry plants as a strategy for managing charcoal rot in a sustainable and environmentally friendly way.
1. Introduction
Charcoal rot disease is caused by the fungus Macrophomina phaseolina. This is a persistent soil pathogen that infects more than 500 species of cultivated and wild plants [1]. Strawberry is one of the crops that can be severely affected by this fungus, whose symptoms include wilting of the foliage, drying and defoliation of the older leaves, and plant death [2]. In Argentina, it has been reported for the first time in strawberry fields at the province of Tucumán [3].
Strawberry is an important fruit that is produced and consumed worldwide. Argentina is the fifth highest producer of strawberries in South America, with around 1300 ha of strawberry grown annually. The importance of the strawberry crop in Argentina lies in its high labor demand, as well as in its industrialization, since 40% of the fruit is consumed processed, with the corresponding added value that this generates to the product [4].
Fungal diseases are the main cause of crop yield losses in the world, with more than 10,000 known fungal species that cause plant death [5]. One way to manage these diseases is through biological control, which can be achieved through a series of strategies (e.g., crop rotation, various types of tillage, adding organic substrate such as compost or manure to the soil before planting, aeration or solarization of the soil). Another effective approach is the deliberate use of specific antagonistic organisms and/or inert biological products extracted from them. In this context, non-pathogenic species of rhizospheric bacteria or PGPR (Plant Growth-Promoting Rhizobacteria) can act against pathogens directly by the production of antibiotics, competition for nutrients, parasitism, and the production of suppressor metabolites (hydrogen cyanide, siderophores), or indirectly by inducing defense mechanisms in the host and generating an induced systemic resistance (ISR) that improves the defensive capacity of plants against the subsequent attack of a broad spectrum of pathogens [6]. ISR is mediated by jasmonic acid/ethylene-signaling pathways, and it is associated with a better defensive capacity, which is called “priming”. Priming does not directly induce resistance-related genes or hormone-related genes nor does it enhance phytohormone production. Instead, it improves sensitivity to hormones rather than their synthesis. Some of the defense responses enhanced by PGPR-mediated ISR can be cell wall reinforcement, oxidative burst, and the accumulation of enzymes related to defense [7,8].
Therefore, biological control is an alternative or complementary strategy to the physical or chemical management of diseases, whose advantages include a lower environmental impact and greater acceptance by the general population [9].
Previous studies have described various bacteria with a biocontrol effect against M. phaseolina in several crops [10]. One of these bacteria is the PGPR Azospirillum brasilense, which reduces the symptoms of charcoal rot in soybean plants [11] and in balsamine (Impatiens balsamina L) [12]. However, in strawberry, there is little information about the biological control of M. phaseolina with PGPRs. A commercial formulation based on Bacillus megaterium and B. laterosporus (Fusbact®) has been reported to control charcoal rot on this crop [13]. Although A. brasilense has been reported as a resistance inducer against the pathogenic fungus Colletotrichum acutatum in strawberry plants [14], the behavior of this PGPR as a biocontrol agent of M. phaseolina in strawberry has not been tested.
Since A. brasilense is effective in controlling M. phaseolina in crops such as soybean or balsamine, and controlling C. acutatum in strawberry plants, we hypothesized that this PGPR could decrease the severity of charcoal rot disease in strawberry plants. The aims of this study were to determine if strains of A. brasilense exert a biocontrol effect over M. phaseolina on strawberry plants and to gain insights on the nature of the biological control mechanisms. That is, this study investigates whether the effect of biocontrol is due to direct mechanisms, such as competition for nutrients, production of antibiotics or enzymatic activities, or indirectly through the induction of plant defenses, as evidenced by structural modifications in plant cells such as stomatal closure and strengthening of the secondary wall by callose and lignin depositions.
2. Materials and Methods
2.1. Plant Material
In vitro micropropagated plants of strawberry (Fragaria x ananassa, Duch.) cv. ‘Pájaro’ were provided by the strawberry BGA (Strawberry Active Germplasm Bank at National University of Tucumán). Healthy plantlets were rooted in pots with sterilized substrate (humus and perlite, 2:1), and maintained at 28 °C, 70% relative humidity (RH), with a light cycle of 16 h (white fluorescent, 350 μmol photons m-2 s-1). In addition, strawberry plants of cv. ‘Camarosa’ from commercial plant providers were used. Plants from both cultivars were 4 months old, approximately.
2.2. Fungal Cultures
Two isolates of M. phaseolina, Fru-SWA and Fru-Cam, previously obtained from strawberry plants from Argentina and characterized by Viejobueno et al. [15], were used. Isolates were grown on potato dextrose agar (PDA) for 4 days in darkness at 30 °C.
2.3. Inoculum
Pure cultures of four strains of A. brasilense were used: REC3 (FJ012319.1), isolated from roots of strawberry plants [16], and 2A1, 2A2, and 2E1, isolated from roots of petunia plants [17]. For each strain, a bacterial suspension containing about 106 CFU ml−1 (OD560 0.2) was prepared in N-free malate (NFb) liquid medium as described in Pedraza et al. [16].
2.4. Biocontrol Related Enzymatic Activity of A. brasilense Strains
Strains of A. brasilense were tested in vitro for the following enzymatic activities: cellulase, amylase, protease, and chitinase. These are cell wall-degrading enzymes that exert a direct inhibitory effect on the hyphal growth of fungal pathogens by degrading their cell wall [6]. The strains were also tested for hydrogen cyanide (HCN) production, which is a toxic volatile compound that inhibits the development of pathogens [18]. The plates were spot inoculated with fresh bacterial cultures grown in liquid NFb medium with stirring at 30 °C for 48 h. The development of a halo zone surrounding the colony was considered a positive result (+, weak activity; ++, moderate activity; +++, strong activity). All experiments were done in duplicate.
Cellulase synthesis: Strains were screened for cellulase production by plating onto M9 agar amended with carboxymethyl cellulose 0.5% and 2 g yeast extract per liter. Colonies surrounded by clear halos upon the addition of Congo red (1 mg mL−1) were considered positive for cellulase production [19].
Amylase synthesis: Strains showing amylase production were identified by spot-inoculating cultures on 1% starch agar plates. After 5 days of incubation at 30 °C, colonies surrounded by a clear halo upon the addition of iodine solution were considered positive for amylase production [20].
Protease synthesis: The protease activity was detected on agar–casein medium, according to the methodology described by Harley and Prescott [21]. The plates were spot inoculated with the four bacterial cultures and incubated at 30 °C for 5 days. Protease activity was detected as a clear zone.
Chitinase synthesis: For chitinase production, strains were tested on agar minimal medium, which was supplemented with colloidal chitin (1.5%). Colonies surrounded by clear halos were considered positive for chitinase production [22].
HCN production: The strains were screened for the production of HCN. King’s medium agar was amended with glycine (4.4 g L−1), and strains were spot inoculated on the center of the plate. A filter paper soaked in a picric acid solution (2.5 g L−1 picric acid and 12.5 g L−1 sodium carbonate) was placed under the lid of the Petri plate. Plates were sealed with paraffin and incubated at 30 °C for 10 days. A change from yellow to orange, red, and brown is recorded as weak, moderate, and strong cyanogenic bacteria, respectively [23].
2.5. Antifungal Activity of A. brasilense Strains
A. brasilense strains were first tested in vitro for their ability to inhibit the growth of M. phaseolina isolates. Assays were performed in sterile Petri dishes containing PDA. Four droplets of inoculum (10 µL) of each bacterial strain were distributed at each end of the PDA plate and incubated at 30 °C for 48 h. Then, a mycelium disc of M. phaseolina, previously grown at 30 °C for 4 days in PDA, was placed in the center of the plate, and the plate was incubated again at 30 °C for 4 days. Plates without bacteria inoculum were used as negative controls. The antifungal activity of the strains was assessed by the presence of inhibitory halos. The experiments were carried out in triplicate.
2.6. Histological Determinations
Histological determinations were performed on strawberry leaves. Only two of the four bacterial strains were chosen for these trials: REC3, for being a reference strain in strawberry crop [16], and 2A1, due to the promising results obtained previously in petunia plants [17]. Strawberry plants cv. ‘Pájaro’ grown in pots (N°10, 300 cc) with sterile substrate were watered with 25 mL of the bacterial suspension of A. brasilense REC3 or 2A1 (106 CFU mL−1). Control plants were watered with 25 mL of sterile distilled water. Fifteen days later, plants were inoculated with M. phaseolina Fru-SWA isolate. We chose this isolate because of its highly virulent behavior in previous pathogenicity tests on strawberry plants (authors’ unpublished data). The inoculation was performed using the toothpick technic described by Edmunds [24] in which sterilized toothpicks (autoclaving at 121 °C for 20 min in potato dextrose broth) were placed onto 4-day-old cultures of the isolate grown on PDA at 30 °C in darkness and further incubated for additional 10 days or until toothpicks were completely covered with microsclerotia. Then, inoculation was carried out by inserting two colonized toothpicks in the crown of the plant. Control plants were treated similarly but using a clean sterilized toothpick. One week before the infection, plants were moved to an infection chamber at 28 °C and 16-h photoperiod (100.5 μmolm−2s−1). Five plants per treatment were used. Samples were collected at 14 days post treatment with bacteria and at 14 days post inoculation (dpi) with fungus. One leaflet was randomly extracted from each of the 5 plants per treatment and immediately fixed in FAA (1:1:8 v/v/v formaldehyde:glacial acetic acid:80% ethyl alcohol). The variables studied were stomata closure as well as lignin and callose deposition. Only fragments of the middle portion of the leaflet were used.
2.6.1. Stomatal Closure
The leaf samples were treated according to the Dizeo de Strittmater technique [25]. The staining used was crystal violet, and the preparations were mounted in water–glycerin (1:1). Abaxial and adaxial epidermis were observed under an optical microscope (Carl Zeiss Axiostar Plus, Göttingen, Germany). Pictures were taken with a digital camera (Canon, PowerShot A620, 7.1 MP), and the width of the stomata aperture was measured with ImageJ software (https://imagej.nih.gov./ij/). For each of the 5 leaflets analyzed per treatment, measurements were made on 20 random optical fields in both adaxial and abaxial surfaces.
2.6.2. Callose Deposition and Lignification
For recording callose deposition, the qualitative method described by Martin [26] was used, with modifications. Cross-sections of the middle portion of the leaflet were treated with HClO 5.25% until clarification. Then, the material was washed and stained with 0.05% aniline blue in 0.15 M KH2PO4, kept in the dark for 2 h, mounted on water–glycerin (1:1), and examined by fluorescence with an microscope (Olympus, model BX43, Tokyo, Japan) equipped with a UV filter U-TVO5xc-3 (365 nm) coupled to a camera Qcolor 5 RTV, 5MP (Olympus, Canada). Callose deposition was identified as refringence in the vascular bundles of the leaves.
For the detection of lignin, the same method was used, but without the staining step. The lignification was observed as a bright light blue color on the secondary walls of the xylem vessels under fluorescent light.
2.7. Induction of Resistance against Charcoal Rot Disease
Two induced resistance (IR) assays against M. phaseolina were performed to assess the protection effect of A. brasilense REC3 and 2A1 strains. The first one was carried out with strawberry plants cv. ‘Pájaro’ and the second one was carried out with strawberry plants cv. ‘Camarosa’. Plants were inoculated with REC3 or 2A1 strains in the same way as described in the “Histological determinations” section. Control plants were watered with sterile distilled water. Fifteen days after bacterial treatment, plants were challenged with M. phaseolina isolates Fru-SWA and Fru-Cam (only in the second trial, to determine if different isolates had an effect on the susceptibility to the disease) using the toothpick technique. Plants were kept in an infection chamber at 28 °C and 16-h photoperiod (100.5 μmolm−2s−1) for 30 days. At the end of the assay, susceptibility to charcoal rot was evaluated as disease severity, using a disease severity rating (DSR) according to Fang et al. [27]: 0 = plant well developed, no disease symptoms; 1 = plant slightly stunted; 2 = plant stunted and yellowing; 3 = plant severely stunted and/or wilting; 4 = majority of leaves of the plant wilted or dead; 5 = plant death.
The experimental design of each experiment was a randomized complete block. The total samples sizes for each treatment were plants only inoculated with M. phaseolina (Mp) (n = 23); inoculated with REC3 and M. phaseolina (REC3+Mp, n = 23), and inoculated with 2A1 and M. phaseolina (2A1+Mp, n = 23). Re-isolations were made from segments of freshly harvested diseased root and/or crown onto PDA plates to confirm infection by the pathogen.
2.8. Statistical Analyses
The stomata closure data were analyzed by a one-way variance analysis test (ANOVA), and the means were compared and separated using LSD multiple comparison test at P ≤ 0.05 with the software Statistix 9.1 (http://www.statistix.com/).
In the induced resistance experiments, control plants (not inoculated with M. phaseolina) showed no disease symptoms, so they were excluded from the analysis. All the disease scores (DS), which ranged from 0 to 5, were transformed by (DS1.5 + 1)/1.5 to resemble a normal distribution [27]. We use a linear model to determine if treatments REC3 + Mp or 2A1 + Mp reduced the severity of the disease compared to plants with no bacterial treatment (Mp). Means were compared using Tukey’s test (P ≤ 0.05) with multcomp::glht [28]. These statistical analyses were performed in R 4.0 [29].
3. Results
3.1. Biocontrol Enzymatic Activity
Biocontrol-related enzymatic activity was tested in the four strains of A. brasilense. In the cellulase production assay, the strain 2A2 showed the highest activity, while REC3 showed the lowest. No strain showed activity in any of the other assays: protease, amylase, chitinase, and HCN production (Table 1).

Table 1.
Enzymatic activities of the four strains of A. brasilense.
3.2. In Vitro Antifungal Activity
In order to verify if the A. brasilense strains were able to inhibit the growth of M. phaseolina isolates, we performed antagonist tests on Petri dishes. No growth inhibition of the fungus was observed in any of the strain/isolate combinations (Figure 1 shows the results for M. phaseolina isolate Fru-SWA).
Figure 1.
In vitro antagonism results of A. brasilense REC3 (b), 2A1 (c), 2A2 (d), and 2E1 (e) strains vs. M. phaseolina isolate Fru-SWA, after 4 d incubation. The control plate was only inoculated with the M. phaseolina isolate Fru-SWA (a).
3.3. Stomatal Closure
Effects of A. brasilense strains on stomatal closure were studied on strawberry plants. Inoculation with 2A1 and REC3 strains reduced stomatal aperture, with (20–23%, respectively) and without (8–11%, respectively) co-inoculation with the pathogenic isolate Fru-SWA from M. phaseolina. Plants inoculated with the fungus increased stomatal aperture by 24–44% (Figure 2).

Figure 2.
Average stomatal aperture in strawberry plants treated with 2A1 or REC3 strains, with and without the inoculation with the M. phaseolina Fru-SWA isolate, and control plants (with and without Fru-SWA). Error bars represent the standard error. Different letters denote significant differences (P ≤ 0.05).
3.4. Lignin and Callose Accumulation
Histological determinations were made to assess lignin and callose accumulation on strawberry leaves. All treatments (including controls) evidenced the presence of lignin in the secondary walls of the xylem vessels, being higher in the plants treated with REC3+Fru-SWA, REC3, and 2A1. The deposition of callose was also higher in plants treated with REC3, REC3+Fru-SWA, and 2A1+Fru-SWA, with strong refringence in the vascular bundles of the leaves. Both in callose and lignin, control plants (with and without Fru-SWA) presented the lowest amount of deposits (Figure 3).

Figure 3.
Accumulation of lignin and callose induced by REC3 and 2A1 strains in strawberry plants of cv. ‘Pájaro’. Lignin (a,c,e,g,i) and callose deposition (b,d,f,h,j) were visualized in foliar tissue of plants treated with water (a,b), Fru-SWA (c,d), 2A1 and 2A1+Fru-SWA (e,f, respectively), REC3 (g,h), and REC3+Fru-SWA (i,j). Arrows point to the vascular bundles of the leaves (xylem and phloem) in callose deposition and the secondary walls of the xylem vessels in lignin deposition. Each micrograph represents a representative example of the five leaflets analyzed coming from five plants.
3.5. Induction of Resistance Against Charcoal Rot Disease
In order to study the protective effect of A. brasilense REC3 and 2A1 strains against two virulent isolates of M. phaseolina (Fru-SWA vs. Fru-Cam), two induction of resistance (IR) assays were carried out on strawberry plants cv. ‘Pájaro’ and ‘Camarosa’. Since the effects of cultivars and isolates on disease severity were not significant according to linear models (P = 0.45 and P = 0.18, respectively), data are shown as the mean of the two isolates and the two cultivars. The results indicate that the severity of the charcoal rot disease caused by M. phaseolina isolates (Mp, DSR = 4.0) was decreased by both REC3 and 2A1 strains (REC3+Mp, DSR = 3.4; 2A1+Mp, DSR = 3.1), when plants were treated with the bacterial strains prior to infection with M. phaseolina isolates (Figure 4).

Figure 4.
Protection effect exerted by A. brasilense REC3 and 2A1 strains on strawberry plants against M. phaseolina. Disease severity rating (DSR) values at 30 dpi on plants treated with REC3, 2A1, or no-bacteria (Mp). Each value represents the mean (n = 23), and error bars indicate the standard error. Values with different letters indicate significant differences at P ≤ 0.05.
4. Discussion
Plant growth-promoting rhizobacteria have some enzymatic activities that are useful for the growth and development of plants. Some of these activities can be also related to biological control, participating actively in the structural degradation of the cell wall of phytopathogenic fungi [6]. In this research, among the enzymes tested, we only detected cellulase activity for the four A. brasilense strains. Several authors also reported activity for this enzyme in various PGPR species [30,31].
The evaluation of the enzymatic activity was complemented with an in vitro antagonism assay against M. phaseolina. No growth inhibition was observed in any of the two isolates exerted by REC3, 2A1, 2A2, or 2E1 strains, suggesting that the possible protection effect of the A. brasilense strains tested on M. phaseolina is not associated with their enzymatic activities, competition for nutrients, or excretion of a toxic secondary metabolite to the medium. Contrarily, a previous study found between 22 and 83% inhibition of M. phaseolina when challenged with A. brasilense [32]. A similar case was reported by Russo et al. [33], who obtained a 50% growth inhibition of the pathogenic fungus Rhizoctonia spp. when confronting with A. brasilense. These cases may be due to an effect of the particular fungal isolate or bacterial strain. However, A. brasilense remains poorly investigated as a biocontrol agent, and the majority of studies place the genera Bacillus, Paenibacillus, Pseudomonas, and Streptomyces as the most widely used biological control agents [6,30,31].
The histological determinations on plants treated with 2A1 and REC3 strains revealed a reduction on the stomatal opening. Other authors also reported a reduction in the stomatal opening in plants of Arabidopsis thaliana and Urochlo aruziziensis inoculated with a strain of A. brasilense [34,35], which is in accordance with our results and supporting the idea that A. brasilense could exert a protection effect through modulation of the stomatal opening in the plant. Stomata regulate the transpiration and gas exchange of vascular plants but also constitute natural openings that provide direct access for numerous pathogens to the leaf tissue. Although there is no record of M. phaseolina entering plants through stomata, a reduction in the stomatal opening would act as a barrier at the entry point of pathogens of aerial dispersion [36]. When infected with M. phaseolina, plants presented greater stomatal aperture. This could be due to the fact that the main symptom of M. phaseolina is plant wilt, and wilt mechanisms induced by fungi can imply reduction in the movement of water, opening of the stomata and loss of the semi-permeability of the membrane [37].
Callose and lignin are the main components of the cell walls in vascular plants. Depositions of callose and lignin cause thickening of the cell wall, constituting the main physical barrier against the successful penetration of invasive pathogens [38]. In this study, plants treated with the A. brasilense REC3 strain, with or without a subsequent infection with the fungus, presented higher depositions of callose and lignin in the vascular bundles of the strawberry leaves compared to control plants. Other authors also found that strawberry plants treated with REC3 strain had higher callose depositions before [39] and after inoculation with the phytopathogenic fungus C. acutatum [14]. Callose and lignin depositions are initially located in the damage zone [40], and they can spread to distal areas mediated by an induced systemic response (ISR) [6]. We observed callose and lignin depositions in the xylem of leaves, although plants had been root-inoculated, suggesting that the protective effect exerted by the bacterial strain is due to an ISR. We did not detect a greater deposition of callose or lignin in plants only inoculated with M. phaseolina Fru-SWA isolate. This is a widespread response of plants to pathogenic fungi, since fungi can rapidly inhibit or inactivate the defense mechanisms of the plant, without letting these structural changes be generated [41]. This lack of defense response against pathogenic fungi has been already described in strawberry against C. acutatum [14,42], which contrasts with the triggering of an ISR response of some avirulent fungal strains [42].
In the IR experiments carried out on strawberry, treatments with REC3 and 2A1 strains reduced charcoal rot severity. These results positioned the strains used as promising resistance inducers against charcoal rot on strawberry plants. This biological control exerted by A. brasilense is likely due to the induction of a systemic defense response in the plant (ISR), which is evidenced in this work by the higher stomatal closure and deposition of callose and lignin. Furthermore, the siderophores produced by REC3 [16] and 2A1 [17] strains could contribute to this resistance effect. Other authors also described the REC3 strain as an inducer of the systemic defense of strawberry plants against anthracnose [14], and Elías et al. [43] proved that inoculation of strawberry plants with the REC3 strain activates the signaling pathway in response to the vegetal hormone ethylene. This hormone acts as a signal molecule for the activation of ISR [44], supporting the premise proposed in the present work, in which the protective effect is due to an ISR. Other authors reported that inoculation with two A. brasilense strains may confer protection to maize plants by the simultaneous induction of jasmonic acid and salicylic acid pathways [45]. This pathways triggers ISR and SAR (systemic acquired resistance), respectively [46,47]. Another strain of A. brasilense was reported as a growth promoter in plum (Prunus cerasifera) as well as a biocontrol agent against the phytopathogen Rhizoctonia spp. [33]. In a field study in Egypt, the incidence of root rot and wilt caused by M. phaseolina in soybean plants was reduced by 30.5–87.5% when using various PGPR (Azotobacter chroococcum, A. brasilense, Bacillus megaterium var. phosphaticum, B. cereus, and Pseudomonas fluorescens) separately or in different combinations [11].
In vitro tests showed that A. brasilense strains did not provoke a direct inhibition of M. phaseolina either by enzymatic activities, competition for nutrients, or the release of toxic substances. However, when assessing indirect biocontrol mechanisms, we found that treatments with these PGPR induced stomatal closure, increased callose and lignin depositions, and reduced the severity of charcoal rot disease on strawberry plants. In conclusion, A. brasilense REC3 and 2A1 strains are capable of inducing a defense response in strawberry plants through physiological and structural modifications. These modifications could explain, in part, the resistance exerted by these strains against the phytopathogen M. phaseolina on strawberry plants. The results obtained in this study provide important information for the difficult task of controlling and managing charcoal rot in a sustainable way, with less impact on the environment and human health.
Author Contributions
Conceptualization, J.V., P.L.A., M.C. and S.M.S.; Data curation, J.V. and P.L.A.; Formal analysis, J.V. and P.L.A.; Funding acquisition, M.C., B.d.l.S. and S.M.S.; Investigation, J.V., P.L.A., M.C., B.d.l.S. and S.M.S.; Methodology, J.V., P.L.A., M.C. and S.M.S.; Resources, P.L.A., M.C., B.d.l.S., M.G.M.-Z. and S.M.S.; Writing—original draft, J.V.; Writing—review and editing, J.V., P.L.A., M.C., B.d.l.S., M.G.M.-Z. and S.M.S. All authors have read and agreed to the published version of the manuscript.
Funding
This research was funded by Universidad Nacional de Tucumán (Program A621), Agencia Nacional de Promoción Científica y Tecnológica (PICT 2017-0653) and INTA (PNHFA 1106073 and 2019-PD-E4-I069-001); by Instituto de Investigación y Formación Agraria y Pesquera de Andalucía (IFAPA) and 80% Fondo Europeo de Desarrollo Regional (FEDER) (PP.AVA 2019.034) and Fundación Miguel Lillo (B-0002-1).
Data Availability Statement
The datasets generated and/or analysed during the current study are available from the corresponding author on reasonable request.
Acknowledgments
Authors are grateful to Strawberry Active Germplasm Bank (BGA) from Universidad Nacional de Tucumán (UNT) and La Loma for providing strawberry plants. We thank Miguel Camacho for his advice in the statistical analyses, Natalia Rodríguez-Berbel for helping in the laboratory and Lelia Bordón for her assistance in design of the micrographs.
Conflicts of Interest
The authors declare no conflict of interest. The funders had no role in the design of the study, in the collection, analyses, or interpretation of data, in the writing of the manuscript, or in the decision to publish the results.
References
- Ijaz, S.; Sadaqat, H.A.; Khan, M.N. A review of the impact of charcoal rot (Macrophomina phaseolina) on sunflower. J. Agric. Sci. 2012, 151, 222–227. [Google Scholar] [CrossRef]
- Koike, S.T. Crown rot of strawberry caused by Macrophomina phaseolina in California. Plant Dis. 2008, 92, 1253. [Google Scholar] [CrossRef] [PubMed]
- Baino, O.M.; Salazar, S.M.; Ramallo, A.C.; Kirschbaum, D.S. First report of Macrophomina phaseolina causing strawberry crown and root rot in Northwestern Argentina. Plant Dis. 2011, 95, 1477. [Google Scholar] [CrossRef] [PubMed]
- Kirschbaum, D.S.; Vicente, C.E.; Cano-Torres, M.A.; Gambardella, M.; Veizaga-Pinto, F.K.; Antunes, L.E.C. Strawberry in South America: From the Caribbean to Patagonia. Acta Hortic. 2017, 1156, 947–956. [Google Scholar] [CrossRef]
- Camejo, D.; Guzmán-Cedeño, Á.; Moreno, A. Reactive oxygen species, essential molecules, during plant–pathogen interactions. Plant Physiol. Biochem. 2016, 103, 10–23. [Google Scholar] [CrossRef] [PubMed]
- Goswami, D.; Thakker, J.N.; Dhandhukia, P.C. Portraying mechanics of plant growth promoting rhizobacteria (PGPR): A review. Cogent Food Agric. 2016, 2, 1127500. [Google Scholar] [CrossRef]
- Romera, F.J.; García, M.J.; Lucena, C.; Martínez-Medina, A.; Aparicio, M.A.; Ramos, J.; Alcántara, E.; Angulo, M.; Pérez-Vicente, R. Induced systemic resistance (ISR) and Fe deficiency responses in dicot plants. Front. Plant Sci. 2019, 10, 287. [Google Scholar] [CrossRef]
- Nie, P.; Li, X.; Wang, S.; Guo, J.; Zhao, H.; Niu, D. Induced Systemic Resistance against Botrytis cinerea by Bacillus cereus AR156 through a JA/ET- and NPR1-Dependent Signaling Pathway and Activates PAMP-Triggered Immunity in Arabidopsis. Front. Plant Sci. 2017, 8, 238. [Google Scholar] [CrossRef]
- Reino, J.L.; Guerrero, R.F.; Hernández-Galán, R.; Collado, I.G. Secondary metabolites from species of the biocontrol agent Trichoderma. Phytochem. Rev. 2008, 7, 89–123. [Google Scholar] [CrossRef]
- Lodha, S.; Mawar, R. Population dynamics of Macrophomina phaseolina in relation to disease management: A review. J. Phytopathol. 2019, 168, 1–17. [Google Scholar] [CrossRef]
- El-Barougy, E.; Awad, N.M.; Turky, A.S.; Hamed, H.A. Antagonistic activity of selected strains of rhizobacteria against Macrophomina phaseolina of soybean plants. Am. J. Agric. Environ. Sci. 2009, 5, 337–347. [Google Scholar]
- Saba, I.; Khan, T.A. Management of disease complex of balsam caused by Meloidogyne javanica and Macrophomina phaseolina by using biofertilisers and pesticides. Arch. Phytopathol. Plant Prot. 2010, 43, 1381–1386. [Google Scholar] [CrossRef]
- Pastrana, A.M.; Basallote-Ureba, M.J.; Aguado, A.; Khalid, A.K.D.I.; Capote, N. Biological control of strawberry soil-borne pathogens Macrophomina phaseolina and Fusarium solani, using Trichoderma asperellum and Bacillus spp. Phytopathol. Mediterr. 2016, 55, 109–120. [Google Scholar] [CrossRef]
- Tortora, M.L.; Díaz-Ricci, J.C.; Pedraza, R.O. Protection of strawberry plants (Fragaria ananassa Duch.) against anthracnose disease induced by Azospirillum brasilense. Plant Soil 2012, 356, 279–290. [Google Scholar] [CrossRef]
- Viejobueno, J.; Medina, J.J.; Aguado, A.; Camacho, M.; Camacho-Sánchez, M.; Salazar, S.M.; de los Santos, B. Caracterización morfológica, cultural y molecular de aislados de Macrophomina phaseolina de España y Argentina. In Proceedings of the Actas de Horticultura 83. IV Jornadas del Grupo Fresón y Otros Frutos Rojos, Valladolid, Spain, 21–22 May 2019; pp. 93–98. [Google Scholar]
- Pedraza, R.O.; Motok, J.; Tortora, M.L.; Salazar, S.M.; Díaz-Ricci, J.C. Natural occurrence of Azospirillum brasilense in strawberry plants. Plant Soil 2007, 295, 169–178. [Google Scholar] [CrossRef]
- Toffoli, L.M. Aplicación de bacterias promotoras del crecimiento vegetal en plantas ornamentales: Respuestas bioquímicas, estructurales y agronómicas de la interacción. PhD Thesis, Universidad Nacional de Tucumán, Tucumán, Argentina, 2019. [Google Scholar]
- Hayat, R.; Ali, S.; Amara, U.; Khalid, R.; Ahmed, I. Soil beneficial bacteria and their role in plant growth promotion: A review. Ann. Microbiol. 2010, 60, 579–598. [Google Scholar] [CrossRef]
- Teather, R.M.; Wood, P.J. Use of Congo red-polysaccharide interactions in enumeration and characterization of cellulolytic bacteria from the bovine rumen. Appl. Environ. Microbiol. 1982, 43, 777–780. [Google Scholar] [CrossRef]
- Cowan, S.T.; Steel, K.J. Manual for the Identification of Medical Bacteria; Cambridge University Press: Cambridge, UK, 1965. [Google Scholar]
- Harley, J.P.; Prescott, L.M. Laboratory Exercises in Microbiology, 6th ed.; McGraw-Hill Science Engineering: New York, NY, USA, 2002. [Google Scholar]
- Mesa, J.; Mateos-Naranjo, E.; Caviedes, M.A.; Redondo-Gómez, S.; Pajuelo, E.; Rodríguez-Llorente, I.D. Endophytic cultivable bacteria of the metal bioaccumulator Spartina maritima improve plant growth but not metal uptake in polluted marshes soils. Front. Microbiol. 2015, 6, 1–15. [Google Scholar] [CrossRef]
- Reetha, A.K.; Pavani, S.L.; Mohan, S. Hydrogen cyanide production ability by bacterial antagonist and their antibiotics inhibition potential on Macrophomina phaseolina (Tassi.) Goid. Int. J. Curr. Microbiol. Appl. Sci. 2014, 3, 172–178. [Google Scholar]
- Edmunds, L.K. Combined relation of plant maturity, temperature, and soil moisture to charcoal stalk rot development in grain sorghum. Phytopathology 1964, 54, 514–517. [Google Scholar]
- D’Ambrogio de Argüeso, A. Manual de Técnicas en Histología Vegetal; Hemisferio Sur. Buenos Aires: Buenos Aires, Argentina, 1986. [Google Scholar]
- Martin, F.W. Staining and observing pollen tubes in the style by means of fluorescence. Stain Technol. 1959, 34, 125–128. [Google Scholar] [CrossRef] [PubMed]
- Fang, X.; Phillips, D.; Li, H.; Sivasithamparam, K.; Barbetti, M.J. Comparisons of virulence of pathogens associated with crown and root diseases of strawberry in Western Australia with special reference to the effect of temperature. Sci. Hortic. 2011, 131, 39–48. [Google Scholar] [CrossRef]
- Hothorn, T.; Bretz, F.; Westfall, P. Simultaneous inference in general parametric models. Biom. J. 2008, 50, 346–363. [Google Scholar] [CrossRef] [PubMed]
- R Core Team. R: A Language and Environment for Statistical Computing; R Foundation for Statistical Computing: Vienna, Austria, 2019; Available online: https://www.R-project.org/ (accessed on 19 January 2020).
- Karimi, E.; Sadeghi, A.; Peyman, A.D.; Dalvand, Y.; Omidvar, M.; Nezhad, M.K. Biocontrol science and technology biocontrol activity of salt tolerant Streptomyces isolates against phytopathogens causing root rot of sugar beet. Biocontrol Sci. Technol. 2012, 22, 333–349. [Google Scholar] [CrossRef]
- Abed, H.; Rouag, N.; Mouatassem, D.; Rouabhi, A. Screening for Pseudomonas and Bacillus antagonistic rhizobacteria strains for the biocontrol of Fusarium wilt of chickpea. Eurasian J. Soil Sci. 2016, 5, 182. [Google Scholar] [CrossRef]
- Perdomo, F.; Alameda, M.; Schroder, E.C. In vitro evaluation of bacteria for the biological control of Macrophomina phaseolina. World J. Microbiol. Biotechnol. 1995, 11, 183–185. [Google Scholar] [CrossRef]
- Russo, A.; Vettori, L.; Felici, C.; Fiaschi, G.; Morini, S.; Toffanin, A. Enhanced micropropagation response and biocontrol effect of Azospirillum brasilense Sp245 on Prunus cerasifera L. clone Mr.S 2/5 plants. J. Biotechnol. 2008, 134, 312–319. [Google Scholar] [CrossRef]
- Cohen, A.; Bottini, R.; Pontin, M.; Berli, F.J.; Moreno, D.; Boccanlandro, H.; Travaglia, C.N.; Piccoli, P.N. Azospirillum brasilense ameliorates the response of Arabidopsis thaliana to drought mainly via enhancement of ABA levels. Physiol. Plant. 2015, 153, 79–90. [Google Scholar] [CrossRef]
- Bulegon, L.G.; Battistus, A.G.; Guimarães, V.F.; Inagaki, A.M.; Offemann, L.C.; Pomini de Souza, A.K.; Rabello de Oliveira, P.S. Physiological responses of Urochloa ruziziensis inoculated with Azospirillum brasilense to severe drought and rehydration conditions. Aust. J. Crop Sci. 2017, 11, 1283–1289. [Google Scholar] [CrossRef]
- Agurla, S.; Gayatri, G.; Raghavendra, A.S. Nitric oxide as a secondary messenger during stomatal closure as a part of plant immunity response against pathogens. Nitric Oxide 2014, 43, 89–96. [Google Scholar] [CrossRef]
- Dehgahi, R.; Subramaniam, S.; Zakaria, L.; Joniyas, A.; Firouzjahi, F.B.; Haghnama, K.; Razinataj, M. Review of research on fungal pathogen attack and plant defense mechanism against pathogen. Int. J. Sci. Res. Agric. Sci. 2016, 2, 197–208. [Google Scholar] [CrossRef]
- Ferreira, R.B.; Monteiro, S.; Freitas, R.; Santos, C.N.; Chen, Z.; Batista, L.M.; Duarte, J.; Borges, A.; Teixeira, A.R. The role of plant defense proteins in fungal pathogenesis. Mol. Plant Pathol. 2007, 8, 677–700. [Google Scholar] [CrossRef] [PubMed]
- Guerrero-Molina, M.F.; Lovaisa, N.C.; Salazar, S.M.; Martínez-Zamora, M.G.; Díaz-Ricci, J.C.; Pedraza, R.O. Physiological, structural and molecular traits activated in strawberry plants after inoculation with the plant growth-promoting bacterium Azospirillum brasilense REC3. Plant Biol. 2014, 17, 766–773. [Google Scholar] [CrossRef] [PubMed]
- Benhamou, N. Elicitor-induced plant defence pathways. Trends Plant Sci. 1996, 1, 233–240. [Google Scholar] [CrossRef]
- Kombrink, E.; Somssich, I.E. Defense responses of plants to pathogens. In Advances in Botanical Research; Academic Press: Cambridge, MA, USA, 1995; pp. 1–34. ISBN 0120059215. [Google Scholar]
- Chalfoun, N.R.; Castagnaro, A.; Díaz Ricci, J.C. Induced resistance activated by a culture filtrate derived from an avirulent pathogen as a mechanism of biological control of anthracnose in strawberry. Biol. Control 2011, 58, 319–329. [Google Scholar] [CrossRef]
- Elías, J.M.; Guerrero-Molina, M.F.; Martínez-Zamora, M.G.; Díaz-Ricci, J.C.; Pedraza, R.O. Role of ethylene and related gene expression in the interaction between strawberry plants and the plant growth-promoting bacterium Azospirillum brasilense. Plant Biol. 2018, 20, 490–496. [Google Scholar] [CrossRef]
- Pieterse, C.M.J.; Leon-Reyes, A.; Van der Ent, S.; Van Wees, S.C.M. Networking by small-molecule hormones in plant immunity. Nat. Chem. Biol. 2009, 5, 308–316. [Google Scholar] [CrossRef]
- Fukami, J.; Ollero, F.J.; de la Osa, C.; Valderrama-Fernández, R.; Nogueira, M.A.; Megías, M.; Hungria, M. Antioxidant activity and induction of mechanisms of resistance to stresses related to the inoculation with Azospirillum brasilense. Arch. Microbiol. 2018, 200, 1191–1203. [Google Scholar] [CrossRef]
- Van Loon, L.C.; Van Strien, E.A. The families of pathogenesis-related proteins, their activities, and comparative analysis of PR-1 type proteins. Physiol. Mol. Plant Pathol. 1999, 55, 85–97. [Google Scholar] [CrossRef]
- Durrant, W.E.; Dong, X. Systemic Acquired Resistance. Annu. Rev. Phytopathol. 2004, 42, 185–209. [Google Scholar] [CrossRef]
Publisher’s Note: MDPI stays neutral with regard to jurisdictional claims in published maps and institutional affiliations. |
© 2021 by the authors. Licensee MDPI, Basel, Switzerland. This article is an open access article distributed under the terms and conditions of the Creative Commons Attribution (CC BY) license (http://creativecommons.org/licenses/by/4.0/).




